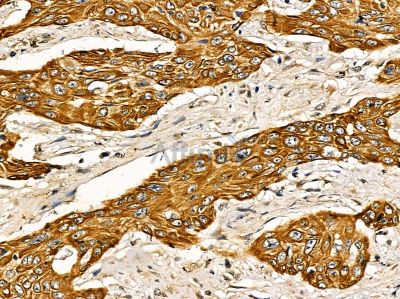
ISG20 Antibody - DF14346 at 1/100 staining human esophageal cancer by IHC-P.

ISG20 Antibody - #DF14346
Related Downloads
Protocols
Product Info
*The optimal dilutions should be determined by the end user. For optimal experimental results, antibody reuse is not recommended.
*Tips:
WB: For western blot detection of denatured protein samples. IHC: For immunohistochemical detection of paraffin sections (IHC-p) or frozen sections (IHC-f) of tissue samples. IF/ICC: For immunofluorescence detection of cell samples. ELISA(peptide): For ELISA detection of antigenic peptide.
Fold/Unfold
CD25; Estrogen regulated transcript 45 protein; Estrogen-regulated transcript 45 protein; HEM45; Interferon stimulated exonuclease gene 20kDa; Interferon stimulated gene 20 kDa protein; Interferon-stimulated gene 20 kDa protein; Isg20; ISG20_HUMAN; Promyelocytic leukemia nuclear body associated protein; Promyelocytic leukemia nuclear body-associated protein ISG20;
Immunogens
A synthesized peptide derived from Human ISG20.
Highly expressed in peripheral blood leukocytes, spleen, thymus, colon and lung. Up regulated by E2 in estrogen receptor-positive breast cancer lines.
- Q96AZ6 ISG20_HUMAN:
- Protein BLAST With
- NCBI/
- ExPASy/
- Uniprot
MAGSREVVAMDCEMVGLGPHRESGLARCSLVNVHGAVLYDKFIRPEGEITDYRTRVSGVTPQHMVGATPFAVARLEILQLLKGKLVVGHDLKHDFQALKEDMSGYTIYDTSTDRLLWREAKLDHCRRVSLRVLSERLLHKSIQNSLLGHSSVEDARATMELYQISQRIRARRGLPRLAVSD
Research Backgrounds
Interferon-induced antiviral exoribonuclease that acts on single-stranded RNA and also has minor activity towards single-stranded DNA. Exhibits antiviral activity against RNA viruses including hepatitis C virus (HCV), hepatitis A virus (HAV) and yellow fever virus (YFV) in an exonuclease-dependent manner. May also play additional roles in the maturation of snRNAs and rRNAs, and in ribosome biogenesis.
Nucleus. Nucleus>Nucleolus. Cytoplasm. Nucleus>Cajal body.
Highly expressed in peripheral blood leukocytes, spleen, thymus, colon and lung. Up regulated by E2 in estrogen receptor-positive breast cancer lines.
Belongs to the exonuclease superfamily.
Restrictive clause
Affinity Biosciences tests all products strictly. Citations are provided as a resource for additional applications that have not been validated by Affinity Biosciences. Please choose the appropriate format for each application and consult Materials and Methods sections for additional details about the use of any product in these publications.
For Research Use Only.
Not for use in diagnostic or therapeutic procedures. Not for resale. Not for distribution without written consent. Affinity Biosciences will not be held responsible for patent infringement or other violations that may occur with the use of our products. Affinity Biosciences, Affinity Biosciences Logo and all other trademarks are the property of Affinity Biosciences LTD.